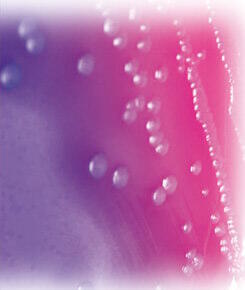

Combattre les infections urinaires et diminuer les risques de récidive
 Les infections urinaires représentent la seconde cause de consultation et de prescription d'antibiotiques, juste derrière les infections respiratoires. L'apparition depuis quelques années de résistances aux antibiotiques, augmentant la fréquence des rechutes et diminuant leur efficacité, a rendu plus urgente la nécessité de trouver des alternatives naturelles.
Les infections urinaires représentent la seconde cause de consultation et de prescription d'antibiotiques, juste derrière les infections respiratoires. L'apparition depuis quelques années de résistances aux antibiotiques, augmentant la fréquence des rechutes et diminuant leur efficacité, a rendu plus urgente la nécessité de trouver des alternatives naturelles.
Le D-mannose, la bromélaïne, les extraits de canneberge, d'hibiscus, de pissenlit et d'orthosiphon agissent de façon synergique pour combattre avec efficacité les micro-organismes responsables des infections urinaires.
On estime qu'une femme sur cinq a eu, a ou aura une infection urinaire à un moment ou un autre de sa vie. Chez l'homme, l'infection urinaire est plus rare et souvent reliée à des troubles de la prostate. Chez la femme, cette affection est intimement liée à son anatomie : les voies génitales et l'anus sont proches de l'urètre, ce petit conduit de trois à quatre centimètres qui permet de vider la vessie. La contamination par des germes intestinaux et vaginaux se produit par simple voisinage et provoque une infection.
L'infection touche les tissus tapissant l'intérieur du système urinaire qui deviennent alors enflammés, irrités et gonflés. Le conduit urinaire enflammé et gonflé peut obstruer partiellement le flux normal et rendre le passage de l'urine difficile et douloureux.
Certaines infections urinaires peuvent être douloureuses et irritantes. D'autres, en particulier si elles sont chroniques, récurrentes ou ne sont pas traitées rapidement et correctement, peuvent être réellement dangereuses.
Dans certaines conditions, les bactéries peuvent remonter dans les reins où l'infection, une pyélonéphrite, peut générer des lésions sérieuses. Une pyélonéphrite chronique est une forme d'inflammation rénale de longue durée avec des symptômes si légers qu'ils peuvent passer inaperçus. Le risque est que la maladie infectieuse inflammatoire ne soit pas détectée et progresse doucement pendant plusieurs années jusqu'à ce que suffisamment de lésions aient été provoquées et créent une insuffisance rénale.
Un univers normalement hostile aux bactéries
Le système urinaire est en temps ordinaire un territoire hostile pour les bactéries, les virus et autres micro-organismes. Ceux qui parviennent à faire leur chemin à travers un système urinaire sain ont toutes les chances de trouver un environnement acide inhospitalier (pH < 5,5). Ils font également l'objet d'attaques des défenses immunitaires de l'organisme. Chez l'homme adulte, en plus, les sécrétions de la prostate contiennent des substances qui ralentissent la multiplication des bactéries dans l'urètre.
Si le micro-organisme parvient à surmonter tous ces obstacles, il devrait normalement être expulsé avec le flux urinaire. Les défenses naturelles antibactériennes sont particulièrement efficaces : lorsque l'on instille des bactéries directement dans la vessie de cochons d'Inde, le simple fait d'uriner expulse 99,9 % des micro-organismes.
Malgré toutes ces barrières de protection, chaque année des millions de personnes, et massivement des femmes, développent des infections du système urinaire.
La plupart des infections débutent lorsqu'une bactérie originaire de l'intestin voyage jusqu'à l'urètre et s'y développe. Si l'infection se limite à l'urètre, c'est une urétrite. Si elle voyage jusqu'à la vessie, c'est une cystite, et si elle atteint les reins, c'est une néphrite ou une pyélonéphrite.
Une fois fixée à la paroi interne du système, la bactérie peut proliférer
Une fois qu'elle a adhéré aux tissus de la paroi interne du système urinaire, la bactérie est capable de proliférer et, ensuite, de provoquer les symptômes cliniques de l'infection. Différentes adhésines situées sur la surface des cellules des organismes pathogènes influencent la fixation des glycoprotéines ou glycolipides complémentaires sur le tissu de l'hôte. On trouve les adhésines sur des structures microscopiques comparables à des cheveux, appelées pili, qui forment des liaisons avec le récepteur cellulaire du site de l'hôte. Chez les bactéries responsables des infections urinaires, ces liaisons sont suffisamment fortes pour résister à l'action nettoyante du flux urinaire.
L'Escherichia coli responsable de 80 % des infections urinaires  L'Escherichia coli, responsable du plus grand nombre d'infections urinaires, fait partie des bactéries « amicales » les plus courantes du système gastro-intestinal où elle favorise la digestion, produit quelques vitamines et se comporte généralement bien, sans nous gêner. Cependant, lorsque l'Escherichia coli et d'autres micro-organismes sortent de l'intestin grêle, ils peuvent pénétrer par l'urètre dans le système urinaire où ils vont s'attacher à la paroi interne de la vessie pour s'y multiplier et se propager.
L'Escherichia coli, responsable du plus grand nombre d'infections urinaires, fait partie des bactéries « amicales » les plus courantes du système gastro-intestinal où elle favorise la digestion, produit quelques vitamines et se comporte généralement bien, sans nous gêner. Cependant, lorsque l'Escherichia coli et d'autres micro-organismes sortent de l'intestin grêle, ils peuvent pénétrer par l'urètre dans le système urinaire où ils vont s'attacher à la paroi interne de la vessie pour s'y multiplier et se propager.
Les infections urinaires dont Escherichia coli n'est pas responsable peuvent être causées par des bactéries comme Chlamidia, Mycoplasma ou Neisseria gonorrhoeae. À la différence d'E. coli, ces micro-organismes sont généralement transmis par contact sexuel et provoquent rarement les infections les plus sérieuses de la vessie et des reins.
Le D-mannose se lie aux molécules d'Escherichia coli qui sont alors évacuées avec l'urine Le D-mannose est un sucre simple, proche du glucose, qui prévient l'adhérence de certaines souches bactériennes aux cellules uroépithéliales de la vessie1. Il permet ainsi de soigner pratiquement 90 % des infections urinaires, sans pour cela tuer la bactérie.
Le D-mannose est un sucre simple, proche du glucose, qui prévient l'adhérence de certaines souches bactériennes aux cellules uroépithéliales de la vessie1. Il permet ainsi de soigner pratiquement 90 % des infections urinaires, sans pour cela tuer la bactérie.
Les parois de la cellule de l'Escherichia coli, comme nous l'avons vu, sont recouvertes de minuscules projections moléculaires, fines comme des cheveux, les adhésines fimbriales, qui s'accrochent comme du velcro à la paroi interne de la vessie et du système urinaire. À l'extrémité de chaque adhésine se trouve une glycoprotéine appelée lectine, programmée pour se lier à la première molécule de mannose qu'elle va rencontrer2.
Les molécules de mannose recouvrent naturellement les mêmes cellules tapissant le canal urinaire à l'intérieur desquelles elles ont été produites. Elles agissent comme des « récepteurs », invitant les adhésines fimbriales de l'E. coli à se lier étroitement au tissu.
Mais si les molécules de mannose dont elles ont tant besoin ne sont plus seulement à la surface des cellules épithéliales mais flottent également tout autour d'elles, dans l'urine, les bactéries E. coli présentes dans le canal urinaire vont s'attacher à la première molécule de mannose rencontrée et seront ensuite évacuées avec l'urine. Les quelques molécules d'E. coli restées accrochées aux molécules de mannose tapissant les cellules épithéliales seront alors des proies faciles pour les globules blancs et autres cellules du système immunitaire3.
Lorsque l'on inocule des bactéries de E. coli dans le système urinaire de rats, en une journée le niveau des bactéries dans les urines des animaux ayant reçu du d-mannose est significativement plus faible4. Chez des souris infectées par E. coli, l'administration d'une substance proche du d-mannose induit une réduction de 90 % des bactéries attachées au système urinaire.
Lorsque l'on avale une dose de D-mannose, ce dernier est absorbé dans le système gastro-intestinal supérieur, mais à un rythme beaucoup plus lent que la plupart des autres sucres. De plus, il n'est pas aussitôt converti en glycogène dans le foie mais, en grande partie inchangé, passe directement dans la circulation sanguine5. Lorsque le sang lourdement chargé en d-mannose traverse les reins, une proportion très importante de sucre est extraite et ajoutée à l'urine. L'urine sucrée par le d-mannose s'écoule des reins à travers l'uretère jusqu'à la vessie puis l'urètre, enduisant littéralement de sucre toute bactérie E. coli flottant sur son chemin, de telle sorte qu'elle ne puisse s'accrocher à aucune autre cellule. Elle décroche également la plupart des E. coli déjà collées à la surface intérieure de la vessie et finit par les faire sortir de l'organisme.
L'extrait d'Hibiscus sabdariffa est riche en polyphénols bactériostatiques
L'Hisbiscus sabdariffa est un arbuste qui pousse dans les zones tropicales des deux hémisphères. En Afrique de l'ouest, ses fleurs rouges sont couramment consommées sous forme de boissons rafraîchissantes. Les décoctions de fleurs sont utilisées depuis des siècles pour renforcer la santé de la vessie et des reins. Les médecins traditionnels africains utilisent le calice de l'hibiscus (l'enveloppe verte du bouton de la fleur) pour acidifier et désodoriser les urines ainsi que pour prévenir les infections urinaires et la formation de calculs rénaux.  L'hibiscus contient un large éventail de puissants composants qui empêchent E. coli d'adhérer à la paroi recouvrant le système urinaire et la vessie. Son calice et sa fleur sont riches en polyphénols bactériostatiques incluant des flavonoïdes, des sambubioanthocyanidines et des proanthocyanidines. La gossypétine, un flavonoïde particulier trouvé dans l'hibiscus, a été identifiée comme un composant antimicrobien spécifique ayant de puissants effets. Tous ces composants naturels sont connus pour leur action antimicrobienne démontrée par de nombreuses études (E. coli, Staphylococcus aureus et Pseudomonas aeruginosa avec des activités similaires à celle du chloramphénicol). L'hibiscus contient également des acides organiques spécifiques et des polysaccharides.
L'hibiscus contient un large éventail de puissants composants qui empêchent E. coli d'adhérer à la paroi recouvrant le système urinaire et la vessie. Son calice et sa fleur sont riches en polyphénols bactériostatiques incluant des flavonoïdes, des sambubioanthocyanidines et des proanthocyanidines. La gossypétine, un flavonoïde particulier trouvé dans l'hibiscus, a été identifiée comme un composant antimicrobien spécifique ayant de puissants effets. Tous ces composants naturels sont connus pour leur action antimicrobienne démontrée par de nombreuses études (E. coli, Staphylococcus aureus et Pseudomonas aeruginosa avec des activités similaires à celle du chloramphénicol). L'hibiscus contient également des acides organiques spécifiques et des polysaccharides.
Deux formulations extraites d'hibiscus ont ainsi montré d'intéressants résultats en termes d'activité antibactérienne sur des souches d'Escherichia coli résistantes à l'ampicilline. De plus, l'étude a fourni des données suggérant que l'utilisation de ces formulations pourrait également aider à combattre la douleur à la miction associée aux infections du système urinaire6.
Un essai clinique en double aveugle, contrôlé contre placebo, a enrôlé soixante et une femmes présentant toutes plus de quatre infections du système urinaire par an, dont l'une est intervenue dans les trois mois précédant le début de l'étude. Ces femmes ont été réparties de façon aléatoire en trois groupes qui ont reçu pendant six mois 200 mg d'un extrait d'hibiscus standardisé à 90 % de polyphénols, 200 mg d'un extrait standardisé à 60 % de polyphénols ou un placebo. Par rapport à celles du groupe témoin, les femmes ayant reçu l'extrait d'hibiscus le plus concentré en polyphénols ont connu une diminution de 77 % des infections ainsi qu'une amélioration globale de leur confort urinaire.
Un autre essai thérapeutique, randomisé, contrôlé et en double aveugle, réalisé sur quarante femmes, a confirmé l'effet bénéfique d'un extrait d'hibiscus sur les récidives de la cystite7.
Selon des recherches in vitro, l'hibiscus diminue les contaminations par E. coli et par Candida albicans. L'effet antimicrobien était immédiat et complet après seulement un jour. De plus, lorsqu'il est comparé à l'extrait de canneberge in vitro, l'extrait d'hibiscus a un effet antimicrobien plus puissant, particulièrement contre C. albicans.
L'extrait concentré de canneberge est utilisé depuis le milieu du xixe siècle pour prévenir et traiter la cystite  La canneberge (Vaccinium macrocarpon) est un arbuste à feuilles persistantes qui pousse dans les tourbières de l'est de l'Amérique du Nord et au Canada. On l'appelle aussi grande airelle rouge. Les Amérindiens consommaient ses fruits sauvages et rares qu'ils appelaient « atoka ». Ils appréciaient ses effets bénéfiques pour désinfecter les plaies, traiter les problèmes de vessie et des reins ou pour l'hygiène bucco-dentaire.
La canneberge (Vaccinium macrocarpon) est un arbuste à feuilles persistantes qui pousse dans les tourbières de l'est de l'Amérique du Nord et au Canada. On l'appelle aussi grande airelle rouge. Les Amérindiens consommaient ses fruits sauvages et rares qu'ils appelaient « atoka ». Ils appréciaient ses effets bénéfiques pour désinfecter les plaies, traiter les problèmes de vessie et des reins ou pour l'hygiène bucco-dentaire.
Dès le milieu du xixe siècle, des médecins allemands contribuèrent à répandre dans le monde moderne l'usage médicinal de la canneberge pour prévenir et traiter la cystite. En 1920, des chercheurs ont remarqué que boire du jus de canneberge rendait les urines plus acides. Comme les infections fréquentes du système urinaire par des bactéries comme Escherichia coli n'aiment pas les environnements acides, ils en ont déduit qu'ils avaient découvert l'explication scientifique de l'usage traditionnel de la canneberge. L'usage médical du jus de canneberge dans le traitement des infections urinaires perd la faveur des médecins après la Seconde Guerre mondiale avec la généralisation de l'emploi des antibiotiques de synthèse. C'est dans les années 1960 que l'on a recommencé à s'y intéresser.
Inhibition de l'adhérence bactérienne Les premières recherches ont été réalisées en 1984. Des chercheurs ont recueilli 77 isolats d'E. coli démontrant l'adhérence à des cellules uroépithéliales, obtenus de femmes n'ayant pas eu d'infection urinaire. L'inhibition de l'adhérence a ensuite été testée. Les données issues de cette étude in vitro suggèrent que le jus de canneberge contient un ou des facteurs inhibant l'adhérence d'E. coli aux cellules épithéliales en interférant avec un composant à la surface de la bactérie. L'étude a également établi que le facteur responsable des propriétés anti-adhérences du jus de canneberge survit au métabolisme normal de l'homme comme à celui de la souris pour être recueilli dans l'urine. Des échantillons d'urine d'hommes et de souris ayant ingéré du jus de canneberge ont significativement perturbé l'adhérence d'E. coli par rapport à ceux des sujets témoins8.
Les premières recherches ont été réalisées en 1984. Des chercheurs ont recueilli 77 isolats d'E. coli démontrant l'adhérence à des cellules uroépithéliales, obtenus de femmes n'ayant pas eu d'infection urinaire. L'inhibition de l'adhérence a ensuite été testée. Les données issues de cette étude in vitro suggèrent que le jus de canneberge contient un ou des facteurs inhibant l'adhérence d'E. coli aux cellules épithéliales en interférant avec un composant à la surface de la bactérie. L'étude a également établi que le facteur responsable des propriétés anti-adhérences du jus de canneberge survit au métabolisme normal de l'homme comme à celui de la souris pour être recueilli dans l'urine. Des échantillons d'urine d'hommes et de souris ayant ingéré du jus de canneberge ont significativement perturbé l'adhérence d'E. coli par rapport à ceux des sujets témoins8.
Diminution du nombre de bactéries
Depuis 1994, des études scientifiques dirigées par l'École médicale de Harvard, à Boston, ont montré que la consommation régulière de canneberge réduit l'incidence des bactéries dans l'urine des femmes. Dans la première étude randomisée, en double aveugle contrôlée par placebo, 153 femmes ont été réparties en deux groupes de façon aléatoire, l'un recevant du jus de canneberge et l'autre un placebo. Au bout de six mois, les résultats ont montré que les buveuses de jus de canneberge avaient eu moins d'infections bactériennes que celles prenant un placebo. Les échantillons d'urine des femmes buvant du jus de canneberge ont montré une diminution de 25 % des bactéries positives par rapport au groupe placebo9.
Un peu plus tard, une plus petite étude croisée, randomisée sur des femmes sexuellement actives âgées de 18 à 45 ans, a utilisé 800 mg d'une préparation solide de canneberge. Elle a constaté une diminution statistiquement significative de la récurrence des infections du système urinaire pour les participantes prenant le supplément à base de canneberge10. En 2001, des chercheurs finlandais ont examiné les effets préventifs d'un jus concentré de canneberge. Les sujets ont été recrutés dans cette étude après avoir été traités pour une infection du système urinaire causée par E. coli. Pendant les six mois de l'étude, cinquante femmes buvant 50 ml par jour de concentré de jus de canneberge ont vu leur risque maximal de développer une infection urinaire diminué de 20 % par rapport à celles prenant un placebo11.
Les actifs responsables de l'activité antiadhésive
Dans l'objectif d'identifier les composants actifs responsables de l'effet antiadhésif bactérien de la canneberge, une équipe de chercheurs a isolé un groupe distinct de composants de la canneberge. Il s'agissait d'un type particulier de tannins concentrés, des proanthocyanidines de type A (PAC), que l'on ne trouve que dans la canneberge. Ils étaient responsables de la destruction des adhésines des bactéries, et plus particulièrement de la bactérie Escherichia coli.
En se fixant sur l'extrémité des filaments d'adhésines, les PAC de la canneberge empêchent les bactéries de s'accrocher aux parois internes de l'organisme, préliminaire indispensable à l'expression de leur pathogénicité. Les bactéries sont alors simplement éliminées avec la miction. Une étude a démontré de façon concluante que les PAC de la canneberge provoquent des altérations invalidantes dans les fimbriales et dans d'autres propriétés de surface des E. coli, diminuant de façon importante leur capacité à s'attacher à la surface des cellules tapissant le système urinaire12.
Une protection contre les E. coli résistantes aux antibiotiques
Inquiets de la résistance croissante aux antibiotiques des bactéries E. coli, les chercheurs ont concentré leur attention sur la recherche de moyens susceptibles de prévenir et de soulager les symptômes des infections du système urinaire. Une étude a observé que les urines provenant de femmes qui buvaient 250 ml par jour d'un cocktail de jus de canneberge prévenaient l'adhérence de 80 % des isolats d'E. coli 39 fimbriae P testés et de 79 % de vingt-quatre souches résistantes aux antibiotiques.  La bromélaïne, par son action anti-inflammatoire, aide à apaiser les irritations et les gonflements
La bromélaïne, par son action anti-inflammatoire, aide à apaiser les irritations et les gonflements
La bromélaïne est une enzyme protéolytique que l'on trouve dans les tiges de l'ananas comme dans son jus de fruit frais. Elle a des propriétés anti-inflammatoires générales et analgésiques qui lui permettent d'aider à apaiser les irritations et gênes provoquées par l'infection urinaire.
Des travaux sur l'animal ont montré qu'elle a aussi des propriétés antibactériennes et qu'elle pourrait aider à empêcher la fixation d'E. coli aux tissus du système urinaire.
La bromélaïne a également la capacité de potentialiser l'effet de certains antibiotiques utilisés dans le traitement des infections urinaires. L'orthosiphon et le pissenlit augmentent le volume urinaire
L'orthosiphon et le pissenlit augmentent le volume urinaire
Le flux urinaire a un rôle essentiel dans le contrôle des infections urinaires. Il expulse les bactéries et rend plus difficile leur ascension vers la vessie et les reins. Le volume du flux urinaire joue un rôle essentiel. Plus la miction est importante, plus les micro-organismes se trouvent dilués. De surcroît, si les mictions sont plus fréquentes grâce à un remplissage rapide de la vessie, les germes sont expulsés avant d'avoir pu se multiplier. Les extraits de pissenlit et d'orthosiphon ont des propriétés légèrement diurétiques qui favorisent l'accroissement du volume urinaire. L'orthosiphon a également un effet légèrement anti-inflammatoire et analgésique.
---------------------------------------------------------------------------
Tous droits de reproduction réservés
Gratuit
Merci de votre visite, avant de partir
inscrivez-vous auClub SuperSmart
d'avantages exclusifs:
- Gratuit : la publication hebdomadaire scientifique "Nutranews"
- Des promotions exclusives aux membres du club



 Format PDF
Format PDF















